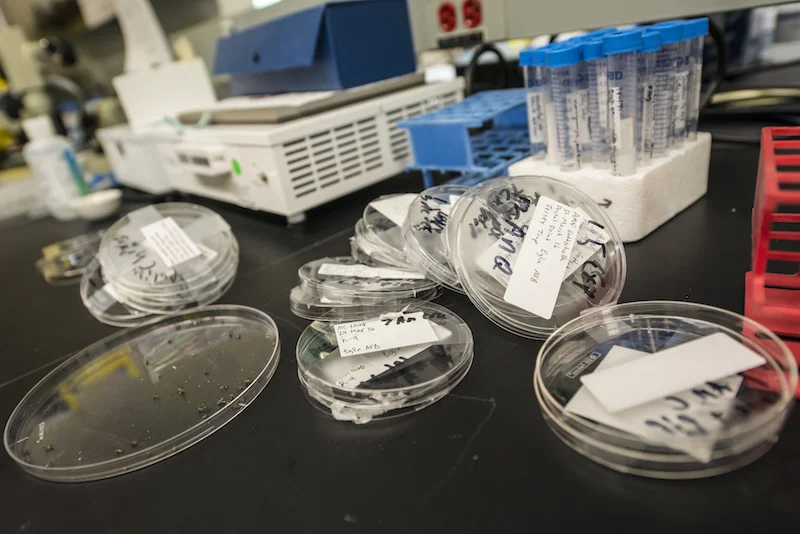

Does Academia Struggle with Integrity?
Academia has a noble reputation; sometimes it can be hard to remember that researchers are just people, as human as everyone else. Here at the UofG, as with other institutions, research integrity is taken very seriously and the University has in place procedures, systems and training to promote high quality, ethical and valuable research. However, in recent years reported instances of research misconduct have risen across the whole sector, with notable high-profile cases creating waves in the media. While the extent of such misconduct remains an area of debate, one thing does appear to be clear—many cases of misconduct are not deliberately fraudulent. So, what is going on and how do we promote and improve research integrity? While research misconduct covers a wide spectrum of actions, a recent Parliamentary Office of Science and Technology (POST) briefing (called a POSTnote) on research integrity defined two broad flavours. Deliberate misconduct covers intentional acts, like falsification, fabrication, cherry-picking data, plagiarism, and even duplicating the same findings in different papers and presenting them as new. While very rare, deliberate misconduct can erode public trust in institutions, siphon money from important (real) research, and even endanger public health. On the other hand, inadvertent errors or poorresearchpractices are also an issue of carelessness, poor understanding of good research practice or corner-cutting to get good results (often under pressure). While less insidious, this later category is considered to be the more common and potentially more serious problem, as small errors can contaminate a field, persisting and spreading without notice until the data are found to be unreproducible. Fortunately, this second category is easier to combat; the vast majority of researchers really do want to produce robust, accurate data; they just might need a little training to help them. However, one issue we have when trying to improve research integrity is a lack of data on how common misconduct really is.
A recent BBC investigation found that between 2012 and 2015 there were at least 300 allegations of misconduct across 23 Russell Group universities (a UK network of 24 high impact research institutions, including the UofG). Of these, about a third of all cases relating to plagiarism, fabrication, piracy and misconduct were upheld. However, perhaps more concerning are the findings of a 2014 study by the Nuffield Council on Bioethics, which indicated that around a quarter of surveyed researchers felt under pressure to circumvent integrity standards at some point in their career. It is not hard to see why. Academia trades on an economy of peer-reviewed publications, leading to a “publish or perish” culture. The across the world, academics are are under pressure to have a good publication record in high-impact journals; you need one to get big grants, renew fixed term contracts, get a permanent academic position… all this can lead someone to cut corners or slightly manipulate data. However, with all this doom and gloom, perhaps we need a little context.
While serious, it is important to appreciate that misconduct allegations relate to a tiny fraction of the Russell Group’s research output. The BBC investigation reported that at least 32 research papers were retracted between 2012-2015 as a result of misconduct. By comparison, the research Institute I work in published at least 28 papers in March 2017 alone, and it is one of the smallest (of seven) in the College of MVLS, which is itself only one of four colleges in only one of 24 Russell Group universities. It is also important to remember that universities are trying to combat misconduct and promote greater consideration of research integrity—including at the UofG.
Miles Padgett, our own Vice-Principal for research and an active physics researcher himself said “Before I became Vice-Principal for Research I thought that investigations into research misconduct only happened elsewhere. Since taking up this post I've realized that that's not the case! At UofG, we are open about our misconduct cases and report them in our annual audit.” However, UofG would obviously rather prevent misconduct from happening, which is why the University actively promotes best practice, as Prof. Padgett explained: “Students here are being trained in an environment that encourages them, right from the start of their research careers, to follow good practice and to discuss what good practice means for their discipline.” To find out more from Prof Padgett, check out this short video on research integrity at UofG.
As with many universities, the UofG takes full advantage of the advice and support offered by the UK Research Integrity Office (UKRIO), an independent charity seeking to promote good practice in academic, scientific and medical research. A number of UofG specific resources have also been made available to staff and students, from a detailed Code of Good Practice in Research to a (now mandatory) Research Integrity workshop for PGRs, which was recently piloted as a webinar to facilitate greater access. The idea is to encourage researchers to continually think about their research practices, so they are producing the highest quality and most ethical work they can. Prevention, as they say, is better than cure.
The Research Integrity workshops in particular are something all PGRs should take full advantage of. These are designed to help early career researchers hit the ground running, providing a space to discuss issues and experiences surrounding topics like collaborations and publication that they would otherwise have to ‘pick up with experience’. One area of academic contention and confusion always discussed is author attribution: should someone be an author or an acknowledgment? In what order should names appear? And how do you handle collaborations across fields with different conventions? PGRs should not be afraid of appearing uninformed, as our own Researcher Development Manager Dr Elizabeth Adams said: “I went on the course the first time assuming I would know everything and came out feeling like I’d been incredibly naïve as a PhD student.” But don’t worry, workshop attendees pick up practical tips throughout, like acquiring a unique ORCID identifier to use alongside your name so all of your research output can be linked (which J. Smith were you again?).
Perhaps one of the most heartening pieces of feedback from these workshops is that PGRs leave feeling more confident in approaching their supervisor to discuss things they don’t yet know (which is not as easy as it sounds!). In fact, the topics covered in this workshop are similar to those in the UofG supervisor training. Research integrity training is important for everyone, not just for the quality of our own work but also to ensure that we are creating an environment that cultivates good research practice and integrity.
Ultimately, improving research integrity is going to be a group activity. As noted in the UofG’s response to a recent House of Commons Science and Technology Committee Inquiry into Research Integrity, it will take the combined actions of higher education institutions, publishers, government, funders and individual researchers themselves. However, there are immediate actions we can all take to improve the integrity of our research, particularly in terms of your experimental designs. Take advantage of the resources around you, be vigilant, and make sure that you and your collaborators are producing the highest quality, most ethical and most valuable research you can.
What concerns or questions do you have about research integrity? Are you happy with the training on offer? Do you want us to cover any topic in more detail? It is OK to be unsure about research ethics and it is essential to ask questions and create a space for discussion, so let us know your thoughts below!
Feature image: Petri dishes full of mosquitos by Airman Magazine (CC BY-NC 2.0), via Flickr.